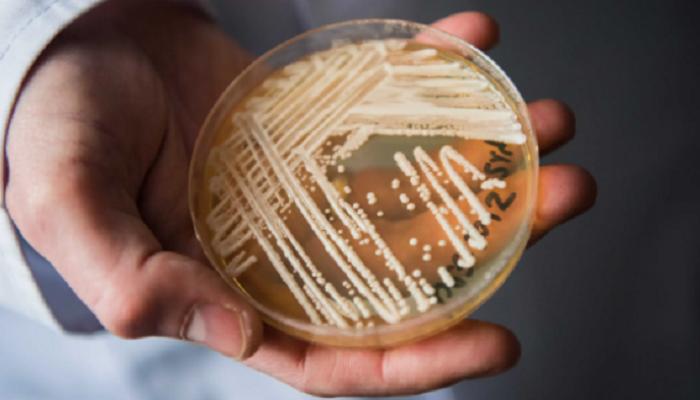

فطر قاتل مقاوم للأدوية يجتاح أوروبا.. والصحة العالمية تصفه بأنه «تهديد للبشرية»
أصدر المركز الأوروبي للوقاية من الأمراض والسيطرة عليها تحذيراً عاجلاً بشأن انتشار واسع لفطر مقاوم للأدوية.
ويعرف الفطر باسم ” كانديدوزايما أوريس “، وسبق أن وصفته منظمة الصحة العالمية بأنه “تهديد خطير للبشرية”.
وبحسب تقرير حديث، أصيب أكثر من 4,000 شخص في أوروبا بهذا الفطر بين عامي 2013 و2023، من بينهم 1,346 حالة العام الماضي وحده، بزيادة قدرها 67% مقارنة بالعام السابق. وتشير البيانات إلى أن نحو 60% من المصابين يفقدون حياتهم خلال 90 يوماً من العدوى.
الفطر الذي ينتشر عادة في المستشفيات ويصيب المرضى ذوي الحالات الحرجة، يمكن أن يهاجم الدماغ والدم والجهاز التنفسي والبولي والعظام والأذن. وما يزيد من خطورته قدرته على البقاء لفترات طويلة على أسطح المستشفيات مثل المعدات الطبية، النوافذ، والأحواض، إضافة إلى مقاومته لمعظم الأدوية المتاحة.
وتسجل إسبانيا واليونان وإيطاليا ورومانيا وألمانيا أعلى معدلات إصابة، في حين أبلغت دول أخرى مثل فرنسا وقبرص عن تفشيات حديثة. وفي عام 2016، اضطرت مستشفى بريطانية إلى إغلاق وحدة العناية المركزة بعد وفاة ثلاثة مرضى وإصابة 50 آخرين بالفطر.
ويرجع الخبراء الزيادة في أعداد الحالات إلى ضعف أنظمة المراقبة الطبية وصعوبة التشخيص المبكر، إضافة إلى ارتفاع درجات الحرارة التي تساعد الفطريات على الانتشار.
ويقول الدكتور ديامانتيس بلاشوراس، رئيس قسم مقاومة الميكروبات في المركز الأوروبي للوقاية من الأمراض والسيطرة عليها: ” الفطر انتقل خلال سنوات قليلة من حالات معزولة إلى انتشار واسع في بعض الدول، لكن الكشف المبكر وتنسيق جهود السيطرة على العدوى ما زالا قادرين على منع تفاقم الوضع”.

ويحذر الأطباء من أن تطوير أدوية مضادة للفطريات يواجه تحديات كبيرة بسبب التشابه بين خلايا الإنسان والفطر، إذ لم تتم الموافقة سوى على أربعة أدوية جديدة خلال العقد الأخير.
وبحسب التقديرات، قد تصل الوفيات الناتجة عن العدوى المقاومة للأدوية إلى 10 ملايين شخص سنوياً بحلول عام 2050، ما يجعل السيطرة على انتشار “الفطر القاتل” أولوية قصوى للسلطات الصحية.
aXA6IDQ1LjE0LjIyNS4xMCA= جزيرة ام اند امز


